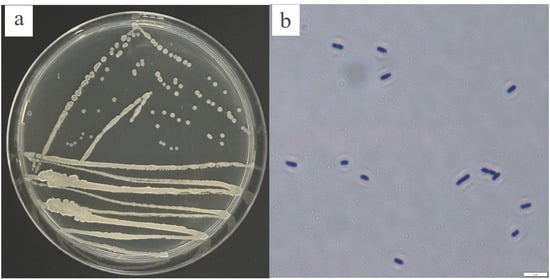

Abstract
Common bacterial blight (CBB), caused by Xanthomonas axonopodis pv. phaseoli (Xap) and Xanthomonas fuscans subsp. fuscans (Xff), is a devastating disease threatening global common bean (Phaseolus vulgaris L.) production. Current reliance on copper-based chemicals has led to environmental toxicity and pathogen resistance, resulting in the need for sustainable alternatives. Here, we report the first biocontrol strain of Bacillus amyloliquefaciens (KY2) that is simultaneously effective against both Xap and Xff. Isolated from the rhizosphere of healthy common bean growing in a high-disease-incidence field, KY2 exhibited broad antagonism, with inhibition zones of 18.17 ± 0.58 mm and 24.00 ± 1.50 mm against Xap and Xff, respectively. Pot experiments revealed a 66.12% curative control efficacy against Xff, slightly lower than the chemical agent 12% Zhongshengmycin. Mechanistically, KY2 alleviated oxidative stress by enhancing antioxidant enzyme activity levels and reducing malondialdehyde accumulation. A transcriptome analysis further uncovered KY2-induced systemic resistance via phenylpropanoid biosynthesis and defense-related pathways. It also demonstrated adaptability to pH 4–8, 20–40 °C, and ≤6% NaCl. However, this study is limited to pot trials, necessitating future field validation to assess practical scalability. These findings establish KY2 as a novel, eco-friendly candidate for CBB management, advancing biocontrol strategies against CBB of bean.
1. Introduction
Common bean (Phaseolus vulgaris L.) is an economically important edible seed cultivated and consumed worldwide [1]. The annual total production is 26 million tons, and it is a main source of protein in the human diet, making it an important food sources [2]. In common bean planting and production processes, Common Bacterial Blight (CBB) is a main disease that infects and damages large areas. The resulting yield loss of common bean is generally 20% to 60%, and in severe cases can reach up to 80%, potentially leading to crop failure. Severe CBB exerts an adverse impact on seed quality, affecting size, shape, color, and germination [3]. CBB occurs worldwide, except for arid tropical areas [4].
CBB, caused by Xanthomonas axonopodis pv. phaseoli (Xap) and Xanthomonas fuscans subsp. fuscans (Xff), severely impacts leaves, stems, and pods of Phaseolus vulgaris L., leading to significant yield and quality losses. Both pathogens are Gram-negative, strictly aerobic, motile rods (0.4–0.7 × 0.7–1.8 μm) with polar flagella. They infect multiple legumes, including Glycine max and Dolichos lablab [5]. CBB thrives and spreads rapidly under hot humid conditions with frequent rain, fog, or dew. The pathogens infect seeds during maternal plant growth [5,6],establishing infected seeds as primary inoculum sources [7]. Post-germination, bacteria asymptomatically colonize seedlings, invade through cotyledons and meristems, and systemically spread via vascular systems, ultimately causing wilting and plant death in the field [8]. CBB pathogens, facilitated by rain and contaminated equipment, primarily invade through stomata and via lesions [9,10]. Furthermore, continuous cropping, severe pest incursions, inadequate soil fertility, and extensive management practices can lead to disease exacerbation. Surveys from 2020 to 2022 in Heilongjiang Province’s Heihe, Daqing, Suihua, and Harbin Regions identified CBB as the primary disease in local bean production, with Xap as the predominant pathogen in leaf isolates, which aligned with Akhavan’s 2013 findings [11].
Currently, there are only a few varieties of common bean that exhibit high resistance to CBB, and no completely immune varieties have been identified. There is no registered bactericide for the management of CBB in common bean, and chemical treatments are primarily confined to copper agents [4]. Furthermore, chemical control fails to substantially diminish pod infection, and it does not increase common bean yields [12]. Copper agents at high concentrations exhibit toxicity to organisms. Copper contamination may also impact crop yield and quality, and as it enters the food chain, it poses potential risks to the health and well-being of animals and humans [13]. Consequently, copper-based fungicides may exert substantial impacts on entire ecosystems [14]. Employing biocontrol microorganisms, as substitutes for chemical pesticides or in a rotation with them for crop disease management, contributes to the reduction in environmental pollution and decelerates the evolution of pathogen resistance. Such applications are constantly proving to be effective within the context of organic agriculture and when integrated with other organic inputs. For example, the combined application of Trichoderma harzianum and plant compost can significantly reduce the incidence of maize Fusarium root rot and increase maize biomass. Such applications verify the potential of the synergistic application of biocontrol microorganisms and organic inputs [15]. Consequently, the screening and application of biocontrol agents have emerged as key areas in the domain of plant disease control.
In recent years, significant efforts have been devoted to the biological control of plant bacterial and fungi diseases. Numerous biocontrol microorganisms, which possess merits including environmental friendliness, non-toxicity to humans and animals, and lack of pathogenic bacterial resistance, have been successfully screened. The related studies have provided strong support for the biological control of plant diseases using bacteria, such as Bacillus cereus (N4; YN917) [16,17], Bacillus altitudinis (3W19, BRHS/S-73) [18,19], Bacillus amyloliquefaciens (DB2; ARP23) [20,21], Bacillus velezensis (L9; YS-AT-DS1) [22,23], Aspergillus sclerotiorum (YCXU) [24], and Streptomyces sp. [25]. In recent years, progress on the biological control of CBB has been made. For example, Sunyar (2024) reported that the control efficacy of B. velezensis BSU-22 against Xap reached 58% [26], but it has no inhibitory effect on Xff. Sallam (2025) [27] used a composite strain of Rahnella aquatilis and Trichoderma orientale, which had a control effect against Xap of 70%. However, it was necessary mixing multiple strains resulted in stability problems, and the plant’s defense response mechanism was not analyzed [27]. To date, there have been no reports indicating that a single strain of B. amyloliquefaciens exhibits a simultaneous antagonistic activity against both Xap and Xff. The KY2 strain screened in this study precisely fills this research gap.
Currently, research on the screening of biocontrol strains of B. amyloliquefaciens against CBB in common bean, the disease control mechanisms, and environmental adaptability remain relatively scarce. This study aimed to isolate and identify rhizospheric bacteria antagonistic to Xap and Xff, evaluate their biocontrol efficacies under pot conditions, and elucidate defense mechanisms via transcriptomic analysis. The research provides new biocontrol resources, and a theoretical basis for the biological control of CBB of common bean and the subsequent development of biocontrol products.
2. Materials and Methods
2.1. Pathogenic Bacterial Strains
Both Xap (GenBank: OR058796) and Xff (GenBank: OR058795) were obtained from the National Coarse Cereals Engineering Research Center. These strains were isolated from the diseased leaves and stems of common bean grown in Heilongjiang Province, China (Table A1). Their pathogenicity levels were determined by injection inoculation before the main experiments [28] (Figure A1).
2.2. Isolation of Bacteria from Rhizosphere Soil
Soil samples were collected from the rhizosphere soils, at a depth of 5–15 cm, of 10 healthy common bean plants in the field. After collection, the soil samples were immediately mixed in pairs to create five composite samples. Samples were placed in sterile, self-sealing bags that were then stored at 4 °C.
After natural drying at 25 °C for 24 h, soil clods were loose and had no obvious clumps. Then, 10 g of soil sample was weighed and added to a triangular flask containing 90 mL of sterile water. The flask was then positioned on a shaker set at 25 °C and 180 r/min for a duration of 30 min. Subsequently, 1 mL of each soil suspension was extracted and then serially diluted with sterile water to achieve gradients of 10−3, 10−4, and 10−5. Immediately, 100 μL from each dilution gradient was taken and spread onto Luria–Bertani (LB) (10 g/L tryptone, 5 g/L yeast extract, 10 g/L NaCl, and 15 g/L agar) agar plates. The plates were then incubated at 30 °C for 24–48 h [29]. All the colonies were selected based on differences in their morphology. The colonies were purified three times on LB plates using the three-zone streaking method they showed a uniform morphology. A single colony from the pure culture was selected and inoculated into LB liquid medium. It was cultured at 30 °C, with a shaking speed of 180 r/min, until the bacterial suspension reached a concentration of 1 × 108. Subsequently, 50% glycerol was added, and each culture was stored at −80 °C for future use.
2.3. Screening of Antagonistic Bacteria
Single colonies of the pathogens Xap and Xff were inoculated into LB medium and incubated at 30 °C for 24 h until the bacterial suspension’s concentration was 1 × 108 cfu/mL. Xap and Xff were added to triangular flasks containing LB agar medium at a 3% inoculum level, shaken well, and then divided into ~15–20 mL/dish. Plates were allowed to cool and solidify, resulting in plates that contained the pathogens of CBB of common bean.
A 6 mm diameter piece of sterile filter paper was placed in the center of each pathogenic bacterial plate, and 5 μL of the isolated and purified bacterial solution was added onto the filter paper, with sterile water serving as a negative control. The 12% Zhongshengmycin wettable powder (Fujian Kaili Biological Products Co., Ltd., Zhangzhou, China) was used as positive control. Plates were incubated at 30 °C for 2–3 days to observe the formation of inhibition zones. The strains that produced an inhibition zone were re-screened using the above method. The diameter of each inhibition zone was calculated using the following formula: (A1 + A2)/2, where A1 and A2 represent the diameter of inhibition zone measured at two different locations using the cross-crossing method [30]. Three biological replicates were performed for each treatment. The strains producing inhibitions zones with the large diameters were selected for subsequent tests.
2.4. Identification of Antagonistic Bacteria
The antagonistic bacteria were streaked on LB agar plate medium using the trilinear method, placed in the incubator at 30 °C for 24 h, and then taken out to observe the morphological features of the strains, including their shape, size, and color. Moreover, the morphological characteristics of the bacteria were examined under a light microscope at 200× magnification. Simultaneously, the physiological and biochemical characteristics of the bacteria were identified in accordance with the Bergey’s Manual of Determinative Bacteriology [31].
The total DNA of the antagonistic bacteria was extracted using the bacterial genomic DNA extraction kit (TransGen Biotech Co., Ltd., Beijing, China). Using universal primers for bacterial 16S rDNA [32] and condensed primers of the gyrB gene [33] (Table A3), PCR amplification was performed using antagonistic bacterial genomic DNA as template. The total reaction system was 50 μL, and the PCR amplification program was set as follows: pre-denaturation at 95 °C for 2 min, 30 cycles of denaturation at 95 °C for 30 s, annealing at 54 °C for 30 s, extension at 72 °C for 60 s, and finally, extension at 72 °C for 10 min. The amplified products were selected for electrophoresis detection on 1% agarose gels, and the PCR products were sequenced by Comate Bioscience Co., Ltd. (Changchun, China) The sequences measured were compared in the BLAST+2.14.0 database of NCBI (http://www.ncbi.nlm.nih.gov/. Accessed on 7 February 2024) and the phylogenetic tree was constructed using Neighbor-joining analysis within MEGA7.0.
2.5. Biological Characterization of Antagonistic Bacteria
The impacts of diverse media, pH levels, temperatures, and salt concentrations on the growth of antagonistic strains were examined. The antagonistic inoculum was added at a proportion of 1% to the following media: Super Optimal Broth (SOB), SOC, NB, and LB, with each being adjusted to pH 7.0–7.2, sterilized at 121 °C for 20 min (the media formulae are detailed in Table A2) and subjected to various temperatures (5–40 °C, in 5 °C intervals), distinct pH values (3.0–10.0 in 1.0-point intervals), and different salt concentrations (0–6%, in 1% intervals). All the treatments were shaken at 180 r/min. A non-bacterial solution served as a blank control, and the OD600 values were measured after 8 h. The experiment was conducted when the OD600 reached 1, indicating approximately 1 × 108 cfu/mL. Each treatment had three independent biological replicates.
2.6. Effects of Antagonistic Bacteria on CBB Control of Common Bean Under Greenhouse Conditions
Common bean seeds were sown in 9 × 9 cm seedling pots with a substrate ratio of 2 soil:1 vermiculite. They were cultured in a greenhouse at 28 °C, with a light-to-dark ratio of 12 h:12 h and 95% relative humidity, and water was supplemented every 2 days. Six common bean plants sown in the same batch and with consistent growth were selected as biological replicates. The 2nd to 3rd compound leaves from each plant were mixed to avoid errors caused by differences in sampling positions, and each indicator was subjected to three technical replicates. When the first three-out compound leaves of potted common bean were fully expanded, they were inoculated with the treatments to observe and determine the inhibitory activities of the antagonistic bacteria against the CBB pathogens Xap and Xff of common bean.
Activate pathogenic bacteria Xap and Xff, as well as the screened antagonistic bacteria, were grown independently on SOC solid plates by incubating them at 30 °C for 12–24 h. Subsequently, single colonies were selected and independently transferred to SOC liquid medium. They were allowed to grow at 30 °C, and 180 r/min for 24–36 h. Then, the concentrations of Xap and Xff were adjusted to 1 × 108 cfu/mL and those of the antagonistic bacteria were adjusted to 2 × 108 cfu/mL. The bacterial suspensions were prepared for subsequent use.
For the therapeutic treatment, 5 μL of the pathogenic bacteria Xap and Xff were injected into the opposite true leaves of common bean using a pipette gun. After 24 h, the leaves were inoculated with an equal volume of the antagonistic KY2 bacterial solution. For the preventive treatment, 5 μL of the antagonistic bacterium was injected into the leaves of the common bean using a pipette tip(Beijing Labgic Technology Co., Ltd., Beijing, China). After 24 h, the leaves were inoculated with an equal volume of the pathogenic bacteria Xap and Xff. Additionally, 12% Zhongshengmycin wettable powder was used as the positive control, being concentrated at the recommended field dose, and a clear water control was also injected. To verify the safety of the antagonist strains, each was injected separately. After inoculation, the seedlings were incubated in an artificial climatic greenhouse chamber at 95% relative humidity and 28 °C for 12 h/20 °C for 12 h until the seedlings developed the disease, after which, the relative humidity was adjusted to 60%. The formation of disease spots was observed for 12 consecutive days.
In accordance with the Zapata rating criteria [34], plant disease levels were recorded, and disease indices were calculated based on the leaf surface area occupied by leaf spots. Disease index = 100 × ∑ (number of diseased leaves at each level × representative value of each level)/(total number of leaves surveyed × representative value of the highest level), and control effect (%) = 100 × (control disease index − treatment disease index)/control disease index.
2.7. Determination of Defensive Enzyme Activity Levels and Malondialdehyde Content in Common Bean Plants Inoculated with Antagonistic Bacteria
The pathogen inoculation was carried out using the spraying method. After 24 h, the antagonistic KY2 bacterial suspension was sprayed. For each treatment, six common bean plants were used (biological replicates), leaves from the same part of each plant were mixed for experimental testing, and each index had three technical replicates. Leaf samples were collected at 0, 2, 4, 6, 8 and 12 days post-inoculation (dpi). The superoxide dismutase (SOD) activity level was determined using the nitrogen blue tetrazolium method [35], the peroxidase (POD) activity level was determined using the guaiacol method [36], the catalase (CAT) activity level was determined using ultraviolet colorimetry [36], and the malondialdehyde (MDA) content was determined using the thiobarbituric acid method [37].
2.8. Transcriptome Analysis of Common Bean Responses to Biocontrol Strain KY2 and Pathogens
Transcriptome samples were collected from leaves of common bean plants inoculated with pathogens at 12 dpi, with three biological replicates per treatment (18 total samples). Treatments included preventive application of biocontrol strain KY2 followed by pathogens Xff/Xap (designated KY2-Xff/Xap), curative application of KY2 after pathogens (Xff/Xap-KY2), and pathogen-only controls (Xff/Xap). Samples were flash-frozen in liquid nitrogen, stored at −80 °C, and RNA was extracted by Hangzhou Kaitai Biotechnology Co., Ltd. (Hangzhou, China). Sequencing libraries were constructed and sequenced on the NovaSeq™ X Plus platform (Illumina, San Diego, CA, USA) using the paired-end 150 bp strategy. Clean reads were aligned to the Phaseolus vulgaris cv. G19833 [38] reference genome via HISAT2 [39], and gene expression levels were quantified using StringTie V 2.2.3. A differential expression analysis was performed using DESeq [40] (negative binomial model) with adjusted p-values (Benjamini–Hochberg method). Differentially expressed genes (DEGs) were functionally annotated via eggNOG for gene ontology (GO) and Kyoto Encyclopedia of Genes and Genomes (KEGG) pathway enrichment, with results visualized as level-2 annotated bar plots [41].
The accuracy of the RNA-Seq analysis was verified using a reverse transcription qRT-PCR assay, which was completed according to the procedures used in transcriptome analysis. Briefly, 20 DEGs were selected to confirm the RNA-Seq data, and the relative fold changes were calculated after normalization using the comparative 2−ΔΔCt method [37]. The thermal cycling conditions were as follows: initial denaturation at 94 °C for 30 s, followed by 45 cycles of denaturation at 94 °C for 5 s, annealing at 60 °C for 15 s, and extension at 72 °C for 15 s.
2.9. Statistical Analyses
For the inhibition zone diameter and pot disease index, Duncan’s new multiple range tests (p < 0.05) were used to compare differences among multiple groups with SPSS 26.0 software. For SOD, POD, and CAT levels, as well as the MDA content, an analysis of variance was used to determine interaction effects between ‘treatment type (prevention/treatment)’ and ‘time (dpi)’, with the significance level set at p < 0.05.
DESeq 2 v1.38.0 software was used to determine DEGs, with the screening criteria for being adjusted p < 0.05 and |log2(fold change)| > 1.
3. Results
3.1. Isolation and Inhibition Effects of Antagonistic Bacteria
Six purified bacterial strains were obtained through the dilution and plating of the soil suspension. Employing the plate dilution method, with the pathogenic bacteria Xap and Xff serving as indicator bacteria, a strain designated as KY2 was selected from six isolates. It exhibited remarkable antagonistic effects against different pathogenic bacteria (Figure 1), with inhibition zones of 18.17 ± 0.58 mm and 24.00 ± 1.5 mm against Xap and Xff, respectively (Table A4).

Figure 1.
The inhibitory effects of antagonistic strain KY2 on CBB of common bean. (a) Xap and (b) Xff.
3.2. Identification of Strain KY2
After strain KY2 was incubated at 30 °C for 24 h, the colony surfaces on LB solid culture dishes exhibited smoothness, regular edges, a circular shape, opacity, and a pale yellow color (Figure 2a). The strain was identified as a Gram-positive bacteria with a rod-shaped morphology (Figure 2b).
Figure 2.
The colony morphology of KY2. (a) A colony of KY2 on LB agar medium. (b) The microscopic morphology of KY2.
The physiological and biochemical tests for gelatin liquefaction, nitrate reduction, V-P, 3% catalase, and sucrose were positive, whereas those for starch hydrolysis, hydrogen sulfide, alginate, methyl red, sorbitol, and inositol were negative. The above characteristics were similar to those of Bacillus sp. according to the Bergey’s Manual of Determinative Bacteriology. The genomic DNA of strain KY2 was used as a template to obtain the 16S rRNA and gyrB gene sequences by PCR amplification. Using MAGA 7.0 software, a phylogenetic tree of strain KY2 was constructed by the Neighbor-joining method, and the 16S rRNA of KY2 (GenBank: OM349482) was placed in the same branch with B. velezensis and B. amyloliquefaciens. It was difficult to distinguish the species of strain KY2 merely through the 16S rRNA (Figure 3). The phylogenetic tree was further analyzed by BLAST in NCBI using the gyrB sequence. It showed the gyrB of strain KY2 (GenBank: PP236909) highest sequence similarity of 99.82% with the gyrB of B. amyloliquefaciens WH1G. KY2 was also in the same branch as B. amyloliquefaciens WH1G (Figure 4). In summary, the culture morphology, physiological, and biochemical characteristics, as well as the phylogenetic analysis of 16S rRNA and gyrB of strain KY2, finally identified strain KY2 as B. amyloliquefaciens. Even though the 16S/gyrB phylogenetic analysis supported KY2 being B. amyloliquefaciens, a multi-locus sequence analysis could further refine the taxonomic resolution.

Figure 3.
Phylogenetic tree of the strain KY2 based on 16S rDNA sequence.

Figure 4.
Phylogenetic tree of the strain KY2 based on gyrB gene sequence.
3.3. The Optimal Fermentation Conditions for Strain KY2
Strain KY2 colonized LB, SOC, SOB, and Nutrient Broth media. Significant differences were noted post-24 h incubation (SOC optimized, showing maximum OD600 = 1.8633). Subsequent assays were conducted using freshly prepared SOC cultures (Figure 5a).

Figure 5.
The optimal fermentation conditions for strain KY2. Effects of different (a) culture media, (b) temperatures, (c) NaCl concentrations, and (d) pH levels. The lowercase letters marked in the figure: groups with no common letters indicate a significant difference (p < 0.05) and groups with common letters indicate no significant difference (p > 0.05).
The bacterial strain KY2 exhibited robust adaptation to temperatures ranging from 20 °C to 40 °C. Absorbance measurements (OD600) confirmed temperature-dependent growth patterns. An accelerated growth rate was observed as temperatures increased from 20 °C to 30 °C, followed by a gradual deceleration between 30 °C and 40 °C. KY2 achieved optimum growth at 35 °C, whereas 30 °C and 40 °C resulted in suboptimal, but comparable, biomass accumulation levels based on maximum optical density (35 °C > 30 °C ≈ 40 °C). Subsequent cultivation steps utilized standardized incubation at 35 °C (Figure 5b).
KY2 had a relatively strong adaptability to NaCl concentration. KY2 grew when the NaCl concentration was between 0% and 6%, but the effects of different NaCl concentrations on its growth were significantly different. An NaCl concentration of 0% was most suitable for KY2 growth, with an OD600 of 1.6953. As the salt concentration increased, the OD600 value of KY2 showed a downward trend. The overall OD600 value of KY2 changed relatively slowly in the 0–4% NaCl range, indicating that KY2 also has a strong growth ability under 4% salt conditions (Figure 5c).
KY2 adapted to a relatively wide pH range and grew within the 4–8 pH range, with better growth in weakly acidic and neutral environments. As the pH increased, the growth rate of KY2 first increased and then slowed down significantly. The optimal pH for KY2 was 5, resulting in an OD600 value of 1.83. Next was pH 6, with an OD600 value of 1.723. When the pH of the medium was 3, 8, 9, or 10, the growth was inhibited, indicating that KY2 is not suitable for growth in extremely acidic or alkaline environments (Figure 5d).
3.4. Control Efficacy of Antagonistic Bacterium KY2
The control efficacy of KY2 on CBB of common bean plants was measured in pot experiments 12 dpi. Plants in the water control group were diseased, with disease indexes of 89.63 and 61.48, respectively. However, for the preventive treatment of inoculating the bacterial KY2 suspension (1 × 108 cfu/mL), the disease indexes of common bean plants were 30.37 and 40.74, respectively, and the control efficacies were 63.64% and 33.73%, respectively. The preventive effect on Xap was not satisfactory. For the curative treatment, the disease indexes of common bean plants were 32.59 and 25.19, respectively, and the control efficacies were 66.12% and 59.47%, respectively (Table 1).

Table 1.
Control efficacy of antagonistic bacterium KY2 in common bean pot experiment.
3.5. Effects of Strain KY2 on Defense-Related Enzyme Activities and MDA Contents in Leaf Tissues of Common Bean
Following the KY2 treatment, the curative groups exhibited distinct dynamic trends in SOD activity. In the Xff subgroup, SOD activity peaked on 0 dpi, followed by a gradual decline from 3 dpi to 6 dpi. It then increased slightly on 9 dpi, before ultimately reaching its lowest level by 12 dpi. Conversely, in the Xff subgroup, SOD activity increased progressively from 0 dpi to a peak at 3 dpi, then declined gradually starting from 6 dpi, reaching its lowest point on 9 dpi, and rebounding slightly by 12 dpi. In contrast, the preventive groups displayed different SOD activity patterns. In the Xap subgroup, activity peaked on 0 dpi, gradually decreased from 3 dpi to 9 dpi, and then rose slightly by 12 dpi. The Xff subgroup showed an initial rise in SOD activity from 0 dpi to a peak at 3 dpi, followed by a steady decline from 6 dpi onward, reaching its lowest level at 12 dpi. At 12 dpi, the SOD activity in the Xap subgroup of the curative group was significantly lower than that of the control, whereas other subgroups exhibited marginally reduced activity levels compared to the control (Figure 6a,b).

Figure 6.
Effects of strain KY2 on defense enzyme activities contents in common bean leaves inoculated with pathogens Xap and Xff. SOD activity after (a) Xap and (b) Xff inoculations. CAT activity after (c) Xff and (d) Xap inoculations.
For the Xap curative subgroup, CAT activity increased from 0 dpi, peaking at 6 dpi, and then, it declined steadily until 12 dpi. In contrast, the Xff subgroup showed the highest CAT activity at 0 dpi, which then gradually decreased from 3 dpi onward. The Xap preventive subgroup exhibited peak CAT activity at 0 dpi. It declined gradually from 3 dpi to 9 dpi and then showed a slight rebound by 12 dpi. Similarly, the Xff subgroup showed peak CAT activity at 0 dpi, followed by a continuous decline from 3 dpi onward (Figure 6c,d).
For the curative Xap subgroup, POD activity was relatively high at 0 dpi, likely reflecting the plant’s initial basal defense response to Xap invasion. It then declined to its lowest level by 3 dpi. From 6 dpi onward, POD activity gradually increased, ultimately peaking at 12 dpi. For the Xff subgroup, POD activity rose progressively from 0 dpi, reached its maximum at 9 dpi, and then declined slightly by 12 dpi. In contrast, the preventive groups showed divergent POD activity patterns. For the Xap subgroup, POD activity began to rise gradually from 0 dpi and continued increasing until reaching its peak at 12 dpi. For the Xff subgroup, POD activity dropped to its lowest point at 3 dpi but then increased steadily from 6 dpi onward, ultimately peaking at 12 dpi. By 12 dpi, both the curative and preventive groups showed lower POD activities in the Xap subgroups than in the Xap controls (Figure 7a,b).

Figure 7.
Effects of strain KY2 on defense enzyme activities and MDA contents in common bean leaves inoculated with pathogens Xap and Xff. Pod activity after (a) Xap and (b) Xff inoculations. MDA contents after (c) Xap and (d) Xff inoculations.
Following the KY2 application, the preventive treatment groups exhibited distinct MDA dynamics. Within the Xff subgroup, MDA levels initially increased before decreasing, culminating in values significantly lower than those of the controls at 12 dpi. Conversely, the Xap subgroup demonstrated an initial reduction in MDA content, reaching its minimum at 6 dpi with marked suppression relative to controls, followed by an upward trend. In the therapeutic treatment group, the Xff subgroup displayed a sustained decline in MDA levels, registering significantly reduced values compared to controls at 6, 9, and 12 dpi. The Xap subgroup manifested a biphasic pattern, MDA levels initially decreased, yielding significantly lower readings than controls at 3, 6, and 9 dpi, but levels then increased, being significantly higher than the controls at 3 and 12 dpi (Figure 7c,d). The enzyme activity and MDA data are detailed in Table A5.
3.6. Analysis of the Transcriptome in Common Bean During Interaction with Biocontrol Strain KY2 and Pathogens
To elucidate the mechanism by which KY2 mediates biocontrol of CBB in common bean, transcriptome sequencing was performed on 18 samples (preventive and therapeutic treatments with three biological replicates each). In raw sequencing data, there is usually a small number of reads containing artificial sequences, such as sequencing primers and adapters. To ensure the accuracy of subsequent analyses, it is necessary to first filter the raw data to remove low-quality data and sequencing adapters that affect data quality and subsequent analyses. A total of 1,204,825,306 raw reads were generated, with 1,149,532,566 clean reads retained after filtering, yielding approximately 172 Gb of data (10 Gb clean reads per sample). Quality metrics included an average GC content of 46.12% (range: 45.8–46.7%), Q20 ≥ 98.98% (98.84–99.09%), and Q30 ≥ 96.73% (96.30–97.02%) (Table A6).
Clean reads were aligned to the P. vulgaris G19833 V1.0 reference genome, achieving total mapping rates of 89.54–96.07% and unique mapping rates of 86.59–92.80% (Table A7). To validate data reliability, gene expression abundance across all 18 samples was analyzed. The distribution trends and dispersion of expression levels indicated minimal variation between samples, confirming data consistency (Figure 8a,d). Hierarchical clustering based on Pearson’s correlation coefficient revealed high reproducibility among biological replicates (R > 0.96), demonstrating strong agreement within treatment groups (Figure 8b). A Principal component analysis further confirmed sample reproducibility, with most biological replicates clustering closely. The outlier Xap-3, which deviated slightly, may reflect minor technical variability (Figure 8c).

Figure 8.
Expression analysis. (a) Comparison of expression levels among different samples. (b) Correlation analysis of samples. (c) PCA of samples. (d) Density distribution diagram of FPKM.
A differential expression analysis was conducted at 12 dpi for preventive (KY2 applied before pathogen inoculation) and therapeutic (KY2 applied after pathogen inoculation) groups, with comparisons defined as follows: KY2-Xff vs. Xff, Xff-KY2 vs. Xff (for Xff strain treatments); KY2-Xap vs. Xap, Xap-KY2 vs. Xap (for Xap strain treatments).
For Xff treatments, KY2-Xff vs. Xff yielded 2409 DEGs (559 upregulated, 1850 downregulated), whereas Xff-KY2 vs. Xff identified 1271 DEGs (364 upregulated, 907 downregulated). For Xap treatments, KY2-Xap vs. Xap yielded 2616 DEGs (1322 upregulated, 1294 downregulated), and Xap-KY2 vs. Xap identified 2095 DEGs (884 upregulated, 1211 downregulated) (Figure 9).

Figure 9.
DEGs and functional enrichment analyses (a) Statistics for all DEGs. (b–e) Volcano plots of DEGs in the following comparisons: (b) KY2-Xff vs. Xff. (c) Xff-KY2 vs. Xff. (d) Xap-KY2 vs. Xap. (e) KY2-Xap vs. Xap.
Preventive groups represent KY2 pre-application, followed by pathogen Xff or Xap inoculation versus pathogen-only controls. Their enriched GO terms reflected a proactive defense priming effect of KY2. Biological Process-enriched terms included plant immune response, microbe symbiont interaction, biotic stress response, antioxidant system activation, and systemic acquired resistance (SAR). This indicates that the KY2 pre-treatment not only triggers immediate immune recognition of subsequent pathogens but also establishes long-term broad-spectrum resistance, as indicated by SAR, consistent with earlier results showing KY2 upregulates antioxidant enzymes SOD and POD to mitigate oxidative stress. Cellular Component terms linked to immune recognition complexes, pathogen-responsive signaling complexes, and defense signal transduction modules were enriched. These components likely serve as structural bases for pathogen detection and rapid defense signal transmission, enabling the plant to quickly respond to pathogen invasion. Molecular Function enrichment focused on secondary metabolite biosynthesis, antioxidant defense, and biofilm stabilization. Secondary metabolites are key antimicrobial substances, whereas biofilm stabilization may help KY2 colonize the leaf surface and compete with pathogens, thereby strengthening its preventive effect.
Therapeutic groups represent pathogen Xff and Xap inoculation first. Their enriched GO terms reflected a targeted stress mitigation response to established infections. Biological Process-enriched terms emphasized biotic stress adaptation, immune signaling amplification, and stress tolerance. Unlike the preventive group’s proactive priming, KY2 here focuses on enhancing the plant’s ability to adapt to existing pathogen damage and amplify weak immune signals triggered by established pathogens. Cellular Component-enriched terms highlighted extracellular secretory protein complexes and immune recognition sites. Extracellular secretory proteins may be directly secreted to inhibit pathogen proliferation at infection sites, whereas immune recognition sites help the plant ‘track’ residual pathogens and prevent further spread. Molecular Function-enriched terms included detoxification, transmembrane transport, and host–microbe interaction. Detoxification helps clear toxins produced by established pathogens, whereas transmembrane transporters may pump antimicrobial substances to infection sites, thereby supporting KY2’s therapeutic role in suppressing existing infections (Figure 10a–d).

Figure 10.
The GO enrichment analysis of upregulated DEGs in the following comparisons: (a) KY2-Xff vs. Xff. (b) Xff-KY2 vs. Xff. (c) Xap-KY2 vs. Xap. (d) KY2-Xap vs. Xap. In the figure above * indicates significant, ** indicates extremely significant and *** indicates extremely significant.
The KEGG pathway analysis revealed significant enrichments of upregulated DEGs in phenylpropanoid biosynthesis, with additional pathways such as linoleic acid metabolism, tryptophan metabolism, flavonoid biosynthesis, isoflavonoid biosynthesis, and sesquiterpenoid/triterpenoid biosynthesis also implicated. These pathways collectively indicate the dynamic reprogramming of plant physiology under biotic stress, including activation of secondary metabolite synthesis and hormonal regulation to balance defense and growth (Figure 11a–d).

Figure 11.
KEGG enrichment analysis of upregulated DEGs in the following comparisons: (a) KY2-Xff vs. Xff. (b) Xff-KY2 vs. Xff. (c) KY2-Xap vs. Xap. (d) Xap-KY2 vs. Xap. In the figure above * indicates significant, ** indicates extremely significant and *** indicates extremely significant.
Notably, preventive treatments enhanced proactive defense mechanisms, including SAR induction, antioxidant system activation, and symbiotic microbe interactions. In contrast, therapeutic treatments primarily triggered passive responses to biotic stress, with weaker emphasis on stress recognition and extracellular defense components. Both groups shared common molecular functions, such as secondary metabolism and antioxidant activity, suggesting overlapping yet distinct strategies for CBB resistance (Figure 12).

Figure 12.
Defense model of KY2-Induced Multi-Layered.
Based on the above analysis, 20 genes were randomly selected to verify the accuracy of RNA-Seq expression data, and qRT-PCR was performed on the same RNA samples initially used for next-generation sequencing. The expression trends of these 20 DEGs were consistent with the RNA-Seq data (Figure A2).
4. Discussion
Bacillus amyloliquefaciens is emerging as a prospective biocontrol agent [42,43,44,45]. However, a critical gap remains because most of the related studies have targeted fungal diseases, whereas the biocontrol of legume bacterial diseases has been rarely reported [26,27,46,47,48,49]. To date, B. amyloliquefaciens has been reported to act as a biocontrol agent for common bean. However, in laboratory experiments, its control efficacy against Xanthomonas citri subsp. fuscans was merely 59% [26]. The control effect of the combined application of R. aquatilis and T. orientale on Xap is 70%, whereas the control effects of single applications are relatively low [27]. Here, the biocontrol of two pathogenic bacteria of common bean, Xap and Xff, is reported for the first time, and its control effects on Xap and Xff reach 66.12% and 59.47%, respectively. Compared with BSU-22, which only resists Xap, and other Bacillus strains from leguminous crops such as YN917, which have no cross-control effect on CBB, KY2 can simultaneously deal with the two dominant pathogenic bacteria of CBB, making it more suitable for the actual field scenario of “mixed occurrence of Xap and Xff”. In this study, we isolated and identified B. amyloliquefaciens strain KY2 from the rhizosphere soil of healthy common bean plants, and it has great potential for the biocontrol of common bean diseases. Its application is in line with the global shift towards eco-friendly agricultural practices.
The antagonistic activity of KY2 was experimentally confirmed. In a plate test, KY2 exhibited strong inhibitory effects on Xap and Xff, producing inhibition zones of 18.17 ± 0.58 mm and 24.00 ± 1.50 mm, respectively, indicating its direct antagonistic effect on the CBB-causing pathogens. This is consistent with previous studies on Bacillus species, such as B. amyloliquefaciens, that showed a strong antagonistic effect on Xanthomonas [49]. In the pot experiment, KY2 showed good control effects. In particular, in the treatment group, the control effects on Xff and Xap were 66.12% and 59.47%, respectively, its effect is slightly lower than that of 12% Zhongshengmycin wettable powder.
Bacillus is considered an effective biocontrol agent against various plant pathogens. Besides directly inhibiting the growth of bacteria and fungi, Bacillus produces three important secondary metabolites, lipopeptides, fengycins, and iturins, which have broad-spectrum antibacterial properties and are effective against bacteria, fungi, and even some viruses [50,51]. Lipopeptides are hydrophilic and lipophilic. By embedding into the microbial cell membranes, they form pores or disrupt the membrane structures, leading to the leakage of cell contents. Some lipopeptides can activate plant SAR, enhancing the immune response to pathogens, which improves host defenses [52]. Under drug stress, Aspergillus niger upregulates the expression of genes related to antioxidant stress, such as ABC transporter proteins and glutathione S-transferases, thereby protecting cells from damage by reactive oxygen species (ROS) [53]. In this study, the upregulation of antioxidant-related genes, such as ABC transporters, was similar [54]. ABC transporter proteins play important roles in drug resistance, stress response, and cell detoxification [55]. They function as extracellular efflux pumps, which can pump drugs out of cells and increase drug resistance [56]. After the addition of Xap and Xff, the expression levels of related transporter protein genes are upregulated to alleviate oxidative stress-related damage and other toxic effects caused by the cyclic lipopeptide antibacterial substances of Bacillus. This indicates that KY2 may produce cyclic lipopeptide antibacterial substances that cause peroxidative damage to the cell membranes of pathogenic bacteria. The transcriptome enrichment supported this hypothesis.
The key antioxidant enzymes SOD and POD scavenge ROS, which accumulates rapidly during pathogen invasion and causes oxidative damage to plant cells [57,58]. The differential temporal activity patterns of these enzymes in preventive and therapeutic treatments suggest that KY2 modulates plant defense responses in a strategy-tailored manner. In the treatment groups, the transient surge in SOD activity reflects rapid ROS scavenging upon pathogen invasion [59]. KY2 likely primes the plant to counteract oxidative bursts triggered by Xff/Xap, because SOD catalyzes superoxide radicals (O2−) into H2O2 and O2 [60]. The subsequent decline suggests resource reallocation to other defense pathways once early oxidative stress is mitigated [61].In contrast, the preventive application of KY2 led to more sustained SOD regulation, likely priming the antioxidant system to suppress ROS accumulation [62]. The POD activity, which is closely linked to lignin synthesis and cell wall reinforcement [21], showed distinct trends. In both treatment strategies, POD activity increased in later stages, suggesting that KY2 enhances structural defenses by promoting cell wall lignification to restrict pathogen spread [63]. KY2 ‘primes’ the plant’s defense system in advance [64], enabling continuous POD accumulation to counteract subsequent Xap invasion, thereby avoiding the transient decline observed in the curative group. This aligns with transcriptome data showing enriched phenylpropanoid biosynthesis pathways, which are major producers of lignin.
The CAT activity, responsible for decomposing hydrogen peroxide, exhibited a general decline in both treatments over time, particularly in the preventive groups. The early CAT burst may be attributed to Xff’s stronger ability to induce rapid ROS production, prompting KY2 to trigger an immediate antioxidant response that diminishes as the pathogen is suppressed [65]. In the preventive subgroup, the initial high activity suggests KY2 primes the plant’s antioxidant system in advance, whereas the late rebound may indicate a secondary defense activation against residual Xap. As a marker of lipid peroxidation, MDA showed significant reductions in most KY2-treated groups, especially in the therapeutic Xff subgroups (6–12 dpi) and preventive Xff groups (12 dpi). This confirms that KY2 alleviates membrane damage caused by pathogen-induced oxidative stress, which is critical for maintaining cell viability and limiting pathogen colonization [36]. The transient increase in MDA in Xap therapeutic groups at 12 dpi may reflect a more aggressive response to Xff, in which controlled ROS accumulation acts as a signaling molecule to activate downstream defense genes [66].
Although the control efficacies of the strains screened in this study are lower than those of chemical agents, the use of beneficial microorganisms to control plant diseases can reduce the use of chemical pesticides. This not only avoids the development of drug resistance in pathogenic bacteria but also reduces the threat to human health posed by pesticide residues in crops and soil. KY2 is a potential biocontrol agent against CBB of common bean and has the function of inhibiting pathogenic bacteria. Its adaptability and induced resistance mechanisms support sustainable agriculture and offer a viable alternative to chemical pesticides. This study has clarified the biocontrol potential of KY2 against CBB in common bean, but it has limitations. The pot experiments were only conducted in a greenhouse, and the performance of KY2 in natural fields has not been verified. The complex environment in natural fields may affect the survival of the strain and reduce the control efficiency. The preventive control effect of KY2 on Xap (33.73%) is significantly lower than that of the therapeutic treatment (59.47%). This limitation is not a strain-specific defect but a common problem where the “viable colonization—metabolite accumulation” of biocontrol bacteria does not match the invasion speed of pathogenic bacteria. Di Rico et al. [67], when evaluating the biocontrol mechanisms of Pseudomonas fluorescens PF05 and Lactiplantibacillus plantarum LMG 23520, found that even highly effective biocontrol strains need to meet two core conditions: viable colonization density reaching the standard and timely accumulation of metabolites. P. fluorescens PF05 needs to reach a viable concentration of 108 CFU/mL to inhibit the spore germination of Fusarium oxysporum, and its cell-free supernatant (CFS) is completely ineffective due to insufficient metabolites. In contrast, the CFS of L. plantarum LMG 23,520 only shows efficacy after 24 h of cultivation, and the early supernatant at 14 h has no inhibitory effect. This is highly consistent with the performance of KY2 in this study, within the interval of only 24 h for preventive treatment, the colonization density of KY2 on the leaf surface of kidney beans may not have reached the critical threshold required to inhibit Xap. Moreover, its core antibacterial substances have not yet accumulated to an effective concentration, resulting in the inability to block the early invasion of Xap. Currently, it is only hypothesized that KY2 antagonizes pathogenic bacteria by producing lipopeptide substances. However, the specific active ingredients have not been identified by HPLC-MS/MS, nor have the functions of key synthetic genes been verified. In future studies, multi-location and multi-growth-stage field experiments will be conducted, combined with qPCR to monitor the colonization dynamics of KY2 in the rhizosphere/leaf surface of common beans. Next, the core antibacterial components of KY2 will be identified through the following process: ‘fermentation broth extraction → HPLC separation → antibacterial activity tracking → MS/MS identification’. Combined with gene knockout technology to eliminate the synthesis of active substances, the direct antagonistic effects on CBB pathogenic bacteria can be verified.
5. Conclusions
This study successfully isolated B. amyloliquefaciens KY2 from the rhizosphere soil of healthy common bean plants and identified it as a promising biocontrol agent against CBB of common bean caused by Xap and Xff. The strain demonstrated significant antagonistic activities against both pathogens, with inhibition zones measuring 18.17 ± 0.58 mm and 24.00 ± 1.50 mm, respectively. In pot experiments, KY2 exhibited robust control efficacies of 66.12% and 59.47% against Xap and Xff, respectively, under therapeutic conditions, comparable to the chemical control agent 12% Zhongshengmycin wettable powder. Notably, KY2 enhanced systemic resistance in common bean plants by modulating defense-related enzymes (SOD, POD, and CAT) and reducing MDA accumulation, thereby alleviating oxidative stress and membrane lipid peroxidation, respectively. A transcriptomic analysis further revealed that KY2 induced the upregulation of genes associated with phenylpropanoid biosynthesis, antioxidant pathways, and SAR, confirming its role in activating plant defense mechanisms. The strain exhibited adaptability to a wide range of environmental conditions (pH 4–8, NaCl up to 6%, and 20–40 °C). These attributes, combined with its eco-friendly profile and lack of resistance-development risks, position KY2 as a sustainable alternative to copper-based chemicals. However, further studies are needed to optimize field application methods, characterize its antimicrobial metabolites (e.g., lipopeptides), and validate long-term efficacy under diverse agroecological conditions. This work provides a foundational framework for developing KY2-based biocontrol products to mitigate CBB and reduce reliance on synthetic pesticides in common bean production systems.
Author Contributions
Conceptualization, M.L., J.C. and Y.G.; Formal analysis, M.L., J.C., X.W. and Y.G.; Investigation, J.C. and X.W.; Data curation, M.L.; Writing—original draft, J.C. and X.W.; Writing—review & editing, M.L. and Y.G.; Supervision, Y.G. All authors have read and agreed to the published version of the manuscript.
Funding
This research was supported by The Construction Project of Double First-Class Initiative in Heilongjiang Province “Green and Low-Carbon of Grain Crops”(LJGXCG2022-107).
Data Availability Statement
The data presented in this study are available in the article and Appendix A and Appendix B. For further inquiries regarding the data, please contact the corresponding author.
Conflicts of Interest
The authors declare no competing interests.
Appendix A

Table A1.
Coordinates of the sample collection.
Table A1.
Coordinates of the sample collection.
| Sample Colle | Coordinates |
|---|---|
| Nenjiang, Heilongjiang Province, China. | 125°17′29.36″ E 49°10′55.26″ N |

Table A2.
Medium formula.
Table A2.
Medium formula.
| Medium | Formula |
|---|---|
| SOB | 20 g/L tryptone, 5 g/L yeast extract, 0.5 g/L NaCl, 2.5 mM KCl, 10 mM MgCl2 |
| SOC | Add 20 mM glucose to SOB (aseptically add after sterilization) |
| NA | Peptone 10 g, beef extract powder 3 g, sodium chloride 5 g, agar |
| MT | Peptone 10 g, anhydrous calcium chloride 0.25 g, tyrosine 0.5 g, agar 15 g, skimmed milk powder 10 g, nystatin 40 mg, cefalexin 80 mg, vancomycin hydrochloride 10 mg, Tween 80 10 mL, deionized water 1000 mL. |
| LB | 10 g/L tryptone, 5 g/L yeast extract, 10 g/L NaCl, and 15 g/L agar |

Table A3.
Primer.
Table A3.
Primer.
| Usage | Gene ID | Forword Sequence (5′-3′) | Reverse Sequence (5′-3′) |
|---|---|---|---|
| 16S rDNA | AGAGTTTGATCCTGGCTCAG | ACGGCTACCTTGTTACGACTT | |
| gyrB | GAAGTCATCATGACCGTTCTGCAYGCNGGNGGNAARTTYGA | AGCAGGGTACGGATGTGCGAGCCRTCNACRTCNGCRTCNGTC | |
| qRT-PCR | PHAVU_003G207300g | CTCCCAAAACAACCGTATCC | TTTTCTCCGAACTCCGATGC |
| PHAVU_009G121000g | CCTTTCACCTCCCACCAAC | GTCGCGCGGGTCGAAAATA | |
| PHAVU_002G139200g | ATAAGCAGCAACTCCAGTCC | GTTCAGCAGGGGAGAGATTG | |
| PHAVU_008G081800g | TAAACAACTCAGCAGTGTCATC | CCCAAACTTGAACACTGGAG | |
| PHAVU_004G013500g | CCTCTCTTCAATCTCCCCAG | ACAGTTTCTGGAGTTCTTCAAT | |
| PHAVU_009G139100g | GGTCATTTTAGATACACGAAAG | CTTCCGAGACGGTTTCGGA | |
| PHAVU_008G022000g | TCCTTCTCCTTGTCTCCCAC | AGGTTGGATCGCAGAAGCC | |
| PHAVU_009G011100g | ACCGTGAGTGGTGTGAAGTG | GGGTATAATGTCCTCGGGC | |
| PHAVU_009G258500g | CTCTTCCCACTCTTCCCCC | CCATAACATTTCGAGCAATCTT | |
| PHAVU_009G181400g | CGCAACTGCTGCTTCTGTTT | AGGTTCCACAGTTGCCTCGC | |
| PHAVU_009G133900g | GGCCCTGGAGAAGTGTTTAA | TCATTTACTGCTTCACGAGCAT | |
| PHAVU_003G060300g | CCTCCACCACAACTTCACAC | TGCAGTAGCCTGAGCCTTC | |
| PHAVU_001G085200g | TTGGCACCCACAAAGACTGT | AGGGTACATCTCTGCCATGC | |
| PHAVU_009G2130001g | CGTCACGATCGGGTCAGG | CTGGTCAATCATCTTGTGCTT | |
| PHAVU_002G196400g | TCTCATCCCCCTCCCTGG | AACTCGCCGGTGAGGTAGG | |
| PHAVU_001G108700g | ACCATAAGAATGTCTGCCACT | CTCATCGAAGTCAGTGGTGT | |
| PHAVU_001G262400g | ATGATGAAGCGGCAGAGCAG | GCTCGCCGTCGCGTCGC | |
| PHAVU_010G066500g | TGGCCAGTGTGAAGTTTGCAT | GCAGTTACAGATGCCACGG | |
| PHAVU_010G079100g | AAGTGGCACAAGAGGTAATGA | AGCTAAAGATATGCATAACACA | |
| Actin | GAAGTTCTCTTCCAACCATCC | TTTCCTTGCTCATTCTGTCCG | |
| PHAVU_003G151700g | GTAATCTTCCTCTAATTGTCATG | CTGAATCCCAAACAACTTTTTAC |

Table A4.
Biocontrol Efficacy of Antagonistic Strains KY2 Against CBB in Common bean.
Table A4.
Biocontrol Efficacy of Antagonistic Strains KY2 Against CBB in Common bean.
| Treatment | Inhibition Zone |
|---|---|
| Xap-KY2 | 18.17 ± 0.58 c |
| Xff-KY2 | 24 ± 1.5 a |
| positive control | |
| Xap-12% zhongshengmycin wettable powder | 20.07 ± 0.17 b |
| Xff-12% zhongshengmycin wettable powder | 19.00 ± 0.29 ab |
| negative control | |
| Xap-sterile water | 0 |
| Xff-sterile water | 0 |
The lowercase letters marked in the figure: groups with no common letters indicate a significant difference (p < 0.05) and groups with common letters indicate no significant difference (p > 0.05).

Table A5.
Enzyme Activity and MDA Data.
Table A5.
Enzyme Activity and MDA Data.
| Indicator | Treatment | 0 d | 3 d | 6 d | 9 d | 12 d |
|---|---|---|---|---|---|---|
| SOD | Xff | 286.63 ± 4.92 ab | 286.94 ± 0.38 b | 268.65 ± 1.80 a | 282.13 ± 0.36 b | 228.99 ± 3.50 c |
| Xap | 215.39 ± 13.77 c | 176.45 ± 4.69 c | 246.74 ± 5.86 a | 363.76 ± 4.44 a | 378.78 ± 3.40 a | |
| Xff-KY2 | 197.64 ± 5.55 c | 324.23 ± 4.58 a | 251.98 ± 15.83 a | 203.82 ± 44.74 c | 206.23 ± 9.54 d | |
| KY2-Xff | 259.94 ± 15.45 b | 158.53 ± 2.36 c | 38.80 ± 10.63 c | 42.23 ± 8.36 d | 183.30 ± 0.28 e | |
| Xap-KY2 | 319.58 ± 9.41 a | 303.67 ± 13.38 b | 178.60 ± 8.14 b | 290.13 ± 15.14 b | 16.27 ± 2.76 f | |
| KY2-Xap | 258.78 ± 18.52 b | 328.51 ± 3.94 a | 267.14 ± 26.79 a | 219.07 ± 8.15 c | 303.86 ± 11.90 b | |
| CAT | Xff | 367.67 ± 39.71 e | 615.83 ± 11.21 cd | 1042.67 ± 25.28 ab | 1399.17 ± 25.83 a | 960.83 ± 14.53 a |
| Xap | 1206.50 ± 10.83 b | 669.33 ± 39.70 c | 778.83 ± 33.49 bc | 1435.83 ± 14.53 a | 1081.67 ± 10.83 a | |
| Xff-KY2 | 1063.33 ± 21.67 c | 299.83 ± 0.17 e | 1324.17 ± 7.26 a | 218.67 ± 3.61 cd | 439.33 ± 119.35 b | |
| KY2-Xff | 1343.33 ± 10.83 a | 837.5 ± 28.87 b | 312.17 ± 0.33 d | 174.83 ± 7.25 d | 508.33 ± 63.05 b | |
| Xap-KY2 | 513.33 ± 7.27 d | 1456.00 ± 10.83 a | 425.17 ± 7.22 cd | 306.67 ± 32.48 c | 69.00 ± 3.62 c | |
| KY2-Xap | 313.33 ± 7.27 e | 514.17 ± 80.12 d | 782.50 ± 22.91 bc | 657.83 ± 86.96 b | 586.50 ± 28.88 b | |
| POD | Xff | 744.33 ± 10.84 a | 800.00 ± 14.43 d | 1580.83 ± 3.63 d | 1775.00 ± 14.43 b | 1540.00 ± 14.65 a |
| Xap | 861.67 ± 7.26 b | 1180.83 ± 3.63 b | 2530.83 ± 10.83 a | 1731.50 ± 3.62 b | 3071.67 ± 11.21 a | |
| Xff-KY2 | 1025.00 ± 14.43 c | 880.83 ± 3.63 c | 1807.50 ± 32.50 c | 2533.33 ± 340.98 a | 2650.83 ± 13.33 a | |
| KY2-Xff | 1456.00 ± 10.83 d | 1772.50 ± 25.54 a | 2144.83 ± 3.77 b | 2335.83 ± 54.70 a | 2740.00 ± 208.43 a | |
| Xap-KY2 | 1831.67 ± 18.05 e | 1775.00 ± 14.43 a | 2144.17 ± 18.05 b | 2532.50 ± 54.14 a | 2391.67 ± 22.05 a | |
| KY2-Xap | 2883.33 ± 50.69 f | 1698.83 ± 54.37 a | 2100.00 ± 43.30 b | 2150.00 ± 28.87 ab | 2975.00 ± 1137.5 a | |
| MDA | Xff | 0.0169 ± 0.0006 d | 0.0248 ± 0.0014 ab | 0.0229 ± 0.0001 a | 0.01560 ± 0.0001 b | 0.0153 ± 0.0011 bc |
| Xap | 0.0269 ± 0.0004 a | 0.0267 ± 0.0008 a | 0.0133 ± 0.0003 cd | 0.0076 ± 0.0008 c | 0.0102 ± 0.0002 cd | |
| Xff-KY2 | 0.0180 ± 0.0001 cd | 0.0230 ± 0.0004 b | 0.0235 ± 0.0019 a | 0.0111 ± 0.0018 c | 0.0072 ± 0.0006 d | |
| KY2-Xff | 0.0238 ± 0.0004 b | 0.0155 ± 0.0001 c | 0.0150 ± 0.0009 c | 0.0089 ± 0.0002 c | 0.0229 ± 0.0002 a | |
| Xap-KY2 | 0.0192 ± 0.0009 c | 0.0112 ± 0.0002 d | 0.0109 ± 0.0003 d | 0.0197 ± 0.0005 a | 0.0183 ± 0.0014 ab | |
| KY2-Xap | 0.0133 ± 0.0005 e | 0.0256 ± 0.0004 a | 0.0197 ± 0.0010 b | 0.0157 ± 0.0013 b | 0.0143 ± 0.0043 bc |
The lowercase letters marked in the figure: groups with no common letters indicate a significant difference (p < 0.05) and groups with common letters indicate no significant difference (p > 0.05).

Table A6.
List of quality of RNA-Seq raw data.
Table A6.
List of quality of RNA-Seq raw data.
| Sample | Raw_Reads | Clean_Reads | Clean_Bases | Q20 | Q30 | GC Content (%) |
|---|---|---|---|---|---|---|
| KY2-Xff_1 | 67,225,828 | 62,818,898 | 9.39 G | 98.944 | 96.6077 | 45.97 |
| KY2-Xff_2 | 64,462,462 | 60,847,580 | 9.09 G | 98.9961 | 96.7721 | 46.03 |
| KY2-Xff_3 | 61,511,076 | 58,371,014 | 8.72 G | 98.9114 | 96.5096 | 45.95 |
| KY2-Xap_1 | 85,534,264 | 83,137,214 | 12.42 G | 99.001 | 96.7998 | 46.03 |
| KY2-Xap_2 | 66,691,204 | 64,751,234 | 9.67 G | 99.0856 | 97.0199 | 46.11 |
| KY2-Xap_3 | 67,643,770 | 65,874,196 | 9.83 G | 98.9647 | 96.6622 | 46.32 |
| Xff_1 | 63,342,416 | 60,007,900 | 8.97 G | 98.9523 | 96.6498 | 46.14 |
| Xff_2 | 62,660,330 | 58,036,698 | 8.68 G | 98.9271 | 96.5859 | 46.31 |
| Xff_3 | 75,266,082 | 70,909,448 | 10.60 G | 98.9741 | 96.7267 | 45.93 |
| Xff-KY2_1 | 63,156,594 | 61,204,210 | 9.13 G | 99.0276 | 96.8601 | 46.07 |
| Xff-KY2_2 | 74,722,198 | 72,744,884 | 10.86 G | 99.0131 | 96.8283 | 46.18 |
| Xff-KY2_3 | 64,109,690 | 63,057,564 | 9.42 G | 99.0322 | 96.8758 | 46.11 |
| Xap_1 | 60,766,880 | 56,759,694 | 8.49 G | 98.9314 | 96.5874 | 45.97 |
| Xap_2 | 69,796,356 | 65,346,890 | 9.77 G | 98.9741 | 96.7199 | 46.2 |
| Xap_3 | 67,231,252 | 62,497,608 | 9.35 G | 98.9414 | 96.5928 | 45.97 |
| Xap-KY2_1 | 55,020,954 | 52,798,766 | 7.90 G | 98.9565 | 96.6354 | 46.04 |
| Xap-KY2_2 | 65,846,438 | 64,705,814 | 9.67 G | 98.996 | 96.7473 | 45.89 |
| Xap-KY2_3 | 69,837,512 | 65,662,954 | 9.81 G | 99.0635 | 96.9723 | 46.24 |

Table A7.
List of mapping results.
Table A7.
List of mapping results.
| Sample | Total Clean | Total Map | Uniquely Map |
|---|---|---|---|
| KY2-Xff_1 | 62,818,898 | 94.67% | 91.53% |
| KY2-Xff_2 | 60,847,580 | 94.45% | 91.32% |
| KY2-Xff_3 | 58,371,014 | 94.51% | 91.48% |
| KY2-Xap_1 | 83,137,214 | 94.43% | 91.44% |
| KY2-Xap_2 | 64,751,234 | 96.07% | 92.80% |
| KY2-Xap_3 | 65,874,196 | 94.99% | 91.77% |
| Xff_1 | 60,007,900 | 89.54% | 86.59% |
| Xff_2 | 58,036,698 | 94.64% | 91.61% |
| Xff_3 | 70,909,448 | 95.06% | 92.12% |
| Xff-KY2_1 | 61,204,210 | 95.80% | 92.67% |
| Xff-KY2_2 | 72,744,884 | 95.50% | 91.99% |
| Xff-KY2_3 | 63,057,564 | 96.00% | 92.58% |
| Xap_1 | 56,759,694 | 94.50% | 91.66% |
| Xap_2 | 65,346,890 | 94.15% | 91.09% |
| Xap_3 | 62,497,608 | 94.56% | 91.59% |
| Xap-KY2_1 | 52,798,766 | 95.45% | 92.28% |
| Xap-KY2_2 | 64,705,814 | 95.78% | 92.45% |
| Xap-KY2_3 | 65,662,954 | 95.08% | 91.56% |
Appendix B

Figure A1.
Injection Inoculation (a) CK, (b) Xff and (c) Xap.

Figure A2.
Elative expression distribution of target DEGs verified by real-time fluorescence qRT-PCR.
References
- Los, F.G.B.; Zielinski, A.A.F.; Wojeicchowski, J.P.; Nogueira, A.; Demiate, I.M. Beans (Phaseolus vulgaris L.): Whole seeds with complex chemical composition. Curr. Opin. Food Sci. 2018, 19, 63–71. [Google Scholar] [CrossRef]
- Kulaz, H.; Najafi, S.; Tuncturk, R.; Tuncturk, M.; Albalawi, M.A.; Alalawy, A.I.; Oyouni, A.A.A.; Alasmari, A.; Poczai, P.; Sayyed, R.Z. Analysis of Nuclear DNA Content and Karyotype of Phaseolus vulgaris L. Genes 2022, 14, 47. [Google Scholar] [CrossRef]
- Marquez, M.L.; Terán, H.; Singh, S.P. Selecting Common Bean with Genes of Different Evolutionary Origins for Resistance to Xanthomonas campestris pv. phaseoli. Crop Sci. 2007, 47, 1367–1374. [Google Scholar] [CrossRef]
- Chen, N.W.G.; Ruh, M.; Darrasse, A.; Foucher, J.; Briand, M.; Costa, J.; Studholme, D.J.; Jacques, M. Common bacterial blight of bean: A model of seed transmission and pathological convergence. Mol. Plant Pathol. 2021, 22, 1464–1480. [Google Scholar] [CrossRef]
- Karavina, C.; Mandumbu, R.; Parwada, C.; Tibugari, H. A review of the occurrence, biology and management of common bacterial blight. J. Agric. Technol. 2011, 7, 1459–1474. [Google Scholar]
- Darsonval, A.; Darrasse, A.; Durand, K.; Bureau, C.; Cesbron, S.; Jacques, M.-A. Adhesion and Fitness in the Bean Phyllosphere and Transmission to Seed of Xanthomonas fuscans subsp. fuscans. Mol. Plant-Microbe Interact. 2009, 22, 747–757. [Google Scholar] [CrossRef]
- Abd-Alla, M.H.; Bashandy, S.R.; Schnell, S. Occurrence of Xanthomonas axonopodis pv. phaseoli, the causal agent of common bacterial blight disease, on seeds of common bean (Phaseolus vulgaris L.) in upper Egypt. Folia Microbiol. 2010, 55, 47–52. [Google Scholar] [CrossRef]
- Darrasse, A.; Bureau, C.; Samson, R.; Morris, C.E.; Jacques, M.-A. Contamination of bean seeds by Xanthomonas axonopodis pv. phaseoli associated with low bacterial densities in the phyllosphere under field and greenhouse conditions. Eur. J. Plant Pathol. 2007, 119, 203–215. [Google Scholar] [CrossRef]
- Beaver, J.S.; Porch, T.G.; Zapata, M. Registration of ‘Badillo’ Light Red Kidney Bean. J. Plant Regist. 2010, 4, 1–4. [Google Scholar] [CrossRef]
- Harveson, R.M.; Schwartz, H.F. Bacterial Diseases of Dry Edible Beans in the Central High Plains. Plant Health Prog. 2007, 8, 35. [Google Scholar] [CrossRef]
- Akhavan, A.; Bahar, M.; Askarian, H.; Lak, M.R.; Nazemi, A.; Zamani, Z. Bean common bacterial blight: Pathogen epiphytic life and effect of irrigation practices. SpringerPlus 2013, 2, 41. [Google Scholar] [CrossRef]
- Singh, S.P.; Muñoz, C.G. Resistance to Common Bacterial Blight amongPhaseolus Species and Common Bean Improvement. Crop Sci. 1999, 39, 80–89. [Google Scholar] [CrossRef]
- Zhou, C.-F.; Wang, Y.-J.; Li, C.-C.; Sun, R.-J.; Yu, Y.-C.; Zhou, D.-M. Subacute toxicity of copper and glyphosate and their interaction to earthworm (Eisenia fetida). Environ. Pollut. 2013, 180, 71–77. [Google Scholar] [CrossRef] [PubMed]
- Prior, R.; Mittelbach, M.; Begerow, D. Impact of three different fungicides on fungal epi- and endophytic communities of common bean (Phaseolus vulgaris) and broad bean (Vicia faba). J. Environ. Sci. Health Part B 2017, 52, 376–386. [Google Scholar] [CrossRef]
- Abbod, M.; Alkhouri, I.; Shahoud, R. Investigating the effects of Trichoderma harzianum and plant compost on maize growth and Fusarium root rot management under greenhouse conditions. DYSONA Appl. Sci. 2025, 6, 30–39. [Google Scholar] [CrossRef]
- Shi, Y. The volatile components from Bacillus cereus N4 can restrain brown rot of peach fruit by inhibiting sporulation of Monilinia fructicola and inducing disease resistance. Postharvest Biol. Technol. 2024, 18, 119. [Google Scholar] [CrossRef]
- Zhou, H.; Ren, Z.; Zu, X.; Yu, X.; Zhu, H.; Li, X.; Zhong, J.; Liu, E. Efficacy of Plant Growth-Promoting Bacteria Bacillus cereus YN917 for Biocontrol of Rice Blast. Front. Microbiol. 2021, 12, 684888. [Google Scholar] [CrossRef] [PubMed]
- Farias, P.; Francisco, R.; Maccario, L.; Herschend, J.; Sørensen, S.J.; Morais, P.V. Metabolic response of tellurite resistant Bacillus altitudinis strain 3W19 highlights the potential as a model organism for bioremediation. Sci. Rep. 2025, 15, 12745. [Google Scholar] [CrossRef]
- Sunar, K.; Dey, P.; Chakraborty, U.; Chakraborty, B. Biocontrol efficacy and plant growth promoting activity of Bacillus altitudinis isolated from Darjeeling hills, India. J. Basic Microbiol. 2015, 55, 91–104. [Google Scholar] [CrossRef]
- Luan, P.; Yi, Y.; Huang, Y.; Cui, L.; Hou, Z.; Zhu, L.; Ren, X.; Jia, S.; Liu, Y. Biocontrol potential and action mechanism of Bacillus amyloliquefaciens DB2 on Bipolaris sorokiniana. Front. Microbiol. 2023, 14, 1149363. [Google Scholar] [CrossRef]
- Puche, R.; Basso, V.; Fumero, M.V.; Medeot, D.; Jofré, E. Antagonistic activity of autochthonous strains of Bacillus amyloliquefaciens and Bacillus velezensis against fungi and oomycetes associated to damping off. Rhizosphere 2025, 33, 101052. [Google Scholar] [CrossRef]
- Quiroga, M.; Guerrero, C.; Botella, M.A.; Barceló, A.; Amaya, I.; Medina, M.I.; Alonso, F.J.; De Forchetti, S.M.; Tigier, H.; Valpuesta, V. A Tomato Peroxidase Involved in the Synthesis of Lignin and Suberin. Plant Physiol. 2000, 122, 1119–1128. [Google Scholar] [CrossRef]
- Hu, Y.; You, J.; Wang, Y.; Long, Y.; Wang, S.; Pan, F.; Yu, Z. Biocontrol efficacy of Bacillus velezensis strain YS-AT-DS1 against the root-knot nematode Meloidogyne incognita in tomato plants. Front. Microbiol. 2022, 13, 1035748. [Google Scholar] [CrossRef]
- Gebily, D.A.S.; Ghanem, G.A.M.; Ragab, M.M.; Ali, A.M.; Soliman, N.E.K.; Abd El-Moity, T.H. Characterization and potential antifungal activities of three Streptomyces spp. as biocontrol agents against Sclerotinia sclerotiorum (Lib.) de Bary infecting green bean. Egypt. J. Biol. Pest. Control 2021, 31, 33. [Google Scholar] [CrossRef]
- Faheem, M. Evaluation of the biocontrol potential of Streptomyces goshikiensis YCXU against Fusarium oxysporum f. sp. niveum. Biol. Control 2015, 81, 101–110. [Google Scholar] [CrossRef]
- Sunyar, B.; Yeşildağ, M.F.; Alma, M.H. Effectiveness of Bacillus and Pseudomonas Strains in Biological Control of Common Bacterial Blight Disease in Common Bean (Phaseolus vulgaris L.). J. Crop Health 2024, 76, 1357–1372. [Google Scholar] [CrossRef]
- Sallam, N.M.A.; Aldayel, M.F. Synergistic effects of Rahnella aquatilis and Trichoderma orientale in biocontrol of common bacterial blight in bean. Egypt. J. Biol. Pest. Control 2025, 35, 9. [Google Scholar] [CrossRef]
- Hu, X.; Wang, J.; Li, R.; Wu, X.; Gao, X.; Li, M. Establishment of an Artificial Inoculation Method of Ustilaginoidea virens Without Damaging the Rice Panicle Sheaths. Plant Dis. 2022, 106, 289–296. [Google Scholar] [CrossRef] [PubMed]
- Feng, X.; Xu, R.; Zhao, N.; Wang, D.; Cun, M.; Yang, B. Isolation, Identification, and Characterization of Endophytic Bacillus from Walnut (Juglans sigillata) Root and Its Biocontrol Effects on Walnut Anthracnose. Agriculture 2022, 12, 2102. [Google Scholar] [CrossRef]
- Bach, E. Evaluation of biological control and rhizosphere competence of plant growth promoting bacteria. Appl. Soil Ecol. 2016, 99, 141–149. [Google Scholar] [CrossRef]
- Whitman, W.B. (Ed.) Bergey’s Manual of Systematics of Archaea and Bacteria, 1st ed.; Wiley: Hoboken, NJ, USA, 2015. [Google Scholar] [CrossRef]
- Wilson, K.H.; Blitchington, R.B.; Greene, R.C. Amplification of bacterial 16S ribosomal DNA with polymerase chain reaction. J. Clin. Microbiol. 1990, 28, 1942–1946. [Google Scholar] [CrossRef]
- Yamamoto, S.; Harayama, S. PCR amplification and direct sequencing of gyrB genes with universal primers and their application to the detection and taxonomic analysis of Pseudomonas putida strains. Appl. Environ. Microbiol. 1995, 61, 1104–1109. [Google Scholar] [CrossRef] [PubMed]
- Zapata, M.; Beaver, J.S.; Porch, T.G. Dominant gene for common bean resistance to common bacterial blight caused by xanthomonas axonopodis pv. phaseoli. Euphytica 2011, 179, 373–382. [Google Scholar] [CrossRef]
- Durak, I.; Yurtarslanl, Z.; Canbolat, O.; Akyol, Ö. A methodological approach to superoxide dismutase (SOD) activity assay based on inhibition of nitroblue tetrazolium (NBT) reduction. Clin. Chim. Acta 1993, 214, 103–104. [Google Scholar] [CrossRef]
- Maehly, A.C. The Assay of Catalases and Peroxidases. In Methods of Biochemical Analysis. 1 Version; Wiley: Hoboken, NJ, USA, 1954; pp. 357–424. [Google Scholar] [CrossRef]
- Cakmak, I.; Horst, W.J. Effect of aluminium on lipid peroxidation, superoxide dismutase, catalase, and peroxidase activities in root tips of soybean (Glycine max). Physiol. Plant. 1991, 83, 463–468. [Google Scholar] [CrossRef] [PubMed]
- Yang, P.; Chang, Y.; Wang, L.; Wang, S.; Wu, J. Regulatory mechanisms of the resistance to common bacterial blight revealed by transcriptomic analysis in common bean (phaseolus vulgaris L.). Front. Plant Sci. 2022, 12, 800535. [Google Scholar] [CrossRef]
- Kim, D.; Paggi, J.M.; Park, C.; Bennett, C.; Salzberg, S.L. Graph-based genome alignment and genotyping with HISAT2 and HISAT-genotype. Nat. Biotechnol. 2019, 37, 907–915. [Google Scholar] [CrossRef] [PubMed]
- Love, M.I.; Huber, W.; Anders, S. Moderated estimation of fold change and dispersion for RNA-seq data with DESeq2. Genome Biol. 2014, 15, 550. [Google Scholar] [CrossRef]
- Yu, G.; Wang, L.-G.; Han, Y.; He, Q.-Y. clusterProfiler: An R Package for Comparing Biological Themes Among Gene Clusters. OMICS J. Integr. Biol. 2012, 16, 284–287. [Google Scholar] [CrossRef]
- Xie, Y.; Zhang, Y.; Lu, Q.; Yu, X.; Zhu, J.; Guo, Q.; Liu, J. Antifungal potential of Bacillus amyloliquefaciens QY-1 against Alternaria alternata in peppers. Biocontrol Sci. Technol. 2025, 35, 909–926. [Google Scholar] [CrossRef]
- Malik, R.; Pawaskar, M.; Temkar, D.; Mohanty, A.K.; Tilve, S.; Kerkar, S. Characterization of a Cyclic Lipopeptide from a Halotolerant Bacillus amyloliquefaciens and its Bioactivity as a Fungicide and a Larvicide. Int. J. Pept. Res. Ther. 2025, 31, 42. [Google Scholar] [CrossRef]
- Liu, X.; John Martin, J.J.; Li, X.; Zhou, L.; Li, R.; Li, Q.; Zhang, J.; Fu, D.; Cao, H. Optimization of the fermentation culture conditions of Bacillus amyloliquefaciens ck-05 using response surface methodology. Front. Microbiol. 2025, 16, 1552645. [Google Scholar] [CrossRef]
- Devi, T.S.; Vijay, K.; Mythili, R.; Wadaan, M.A.; Manivinoth, V.; Kim, W.; Kavitha, T. Optimized Production and Characterization of Auxin by Bacillus amyloliquefaciens (TSP11) for Plant Growth Promotion. J. Basic Microbiol. 2025, 65, e70010. [Google Scholar] [CrossRef]
- Liu, D.; Li, K.; Hu, J.; Wang, W.; Liu, X.; Gao, Z. Biocontrol and Action Mechanism of Bacillus amyloliquefaciens and Bacillus subtilis in Soybean Phytophthora Blight. Int. J. Mol. Sci. 2019, 20, 2908. [Google Scholar] [CrossRef]
- Baard, V.; Bakare, O.O.; Daniel, A.I.; Nkomo, M.; Gokul, A.; Keyster, M.; Klein, A. Biocontrol Potential of Bacillus subtilis and Bacillus tequilensis against Four Fusarium Species. Pathogens 2023, 12, 254. [Google Scholar] [CrossRef] [PubMed]
- Chen, X.; Zhang, Y.; Chao, S.; Song, L.; Wu, G.; Sun, Y.; Chen, Y.; Lv, B. Biocontrol potential of endophytic Bacillus subtilis A9 against rot disease of Morchella esculenta. Front. Microbiol. 2024, 15, 1388669. [Google Scholar] [CrossRef] [PubMed]
- Cui, L.; Yang, C.; Wang, Y.; Ma, T.; Cai, F.; Wei, L.; Jin, M.; Osei, R.; Zhang, J.; Tang, M. Potential of an endophytic bacteria Bacillus amyloliquefaciens 3–5 as biocontrol agent against potato scab. Microb. Pathog. 2022, 163, 105382. [Google Scholar] [CrossRef]
- Felipe, V.; Bianco, M.I.; Terrestre, M.; Mielnichuk, N.; Romero, A.M.; Yaryura, P.M. Biocontrol of tomato bacterial spot by novel Bacillus and Pseudomonas strains. Eur. J. Plant Pathol. 2021, 160, 935–948. [Google Scholar] [CrossRef]
- Guo, Z.; Lu, Z.; Liu, Z.; Zhou, W.; Yang, S.; Lv, J.; Wei, M. Difference in the Effect of Applying Bacillus to Control Tomato Verticillium Wilt in Black and Red Soil. Microorganisms 2024, 12, 797. [Google Scholar] [CrossRef]
- Sreedharan, S.M.; Rishi, N.; Singh, R. Microbial lipopeptides: Properties, mechanics and engineering for novel lipopeptides. Microbiol. Res. 2023, 271, 127363. [Google Scholar] [CrossRef]
- Meyer, V.; Damveld, R.A.; Arentshorst, M.; Stahl, U.; Van Den Hondel, C.A.M.J.J.; Ram, A.F.J. Survival in the Presence of Antifungals. J. Biol. Chem. 2007, 282, 32935–32948. [Google Scholar] [CrossRef]
- Sokol-Anderson, M.L.; Brajtburg, J.; Medoff, G. Amphotericin B-Induced Oxidative Damage and Killing of Candida albicans. J. Infect. Dis. 1986, 154, 76–83. [Google Scholar] [CrossRef]
- Wolfger, H.; Mamnun, Y.M.; Kuchler, K. Fungal ABC proteins: Pleiotropic drug resistance, stress response and cellular detoxification. Res. Microbiol. 2001, 152, 375–389. [Google Scholar] [CrossRef] [PubMed]
- Moran, G.P.; Anderson, M.Z.; Myers, L.C.; Sullivan, D.J. Role of Mediator in virulence and antifungal drug resistance in pathogenic fungi. Curr. Genet. 2019, 65, 621–630. [Google Scholar] [CrossRef] [PubMed]
- Sicard, A.; Merfa, M.V.; Voeltz, M.; Zeilinger, A.R.; De La Fuente, L.; Almeida, R.P.P. Discriminating between viable and membrane-damaged cells of the plant pathogen Xylella fastidiosa. PLoS ONE 2019, 14, e0221119. [Google Scholar] [CrossRef]
- Huchzermeyer, B.; Menghani, E.; Khardia, P.; Shilu, A. Metabolic Pathway of Natural Antioxidants, Antioxidant Enzymes and ROS Providence. Antioxidants 2022, 11, 761. [Google Scholar] [CrossRef]
- García, I.; Rosas, T.; Bejarano, E.R.; Gotor, C.; Romero, L.C. Transient Transcriptional Regulation of the CYS-C1 Gene and Cyanide Accumulation upon Pathogen Infection in the Plant Immune Response. Plant Physiol. 2013, 162, 2015–2027. [Google Scholar] [CrossRef]
- Barzegar, A.; Moosavi-Movahedi, A.A. Intracellular ROS Protection Efficiency and Free Radical-Scavenging Activity of Curcumin. PLoS ONE 2011, 6, e26012. [Google Scholar] [CrossRef]
- Dutta, A.; Choudhary, P.; Gupta-Bouder, P.; Chatterjee, S.; Liu, P.-P.; Klessig, D.F.; Raina, R. Arabidopsis SMALL DEFENSE-ASSOCIATED PROTEIN 1 Modulates Pathogen Defense and Tolerance to Oxidative Stress. Front. Plant Sci. 2020, 11, 703. [Google Scholar] [CrossRef]
- Espinosa-Vellarino, F.L.; Garrido, I.; Ortega, A.; Casimiro, I.; Espinosa, F. Response to Antimony Toxicity in Dittrichia viscosa Plants: ROS, NO, H2S, and the Antioxidant System. Antioxidants 2021, 10, 1698. [Google Scholar] [CrossRef]
- Sun, T.; Yang, W.; Zhang, W.; Liu, Y.; Li, L.; Cheng, S.; Chen, G. Phenylpropanoid pathway mediated the defense response of ‘Korla’ fragrant pear against Alternaria alternata infection. Postharvest Biol. Technol. 2025, 220, 113318. [Google Scholar] [CrossRef]
- Islam, M.T.; Gan, H.M.; Ziemann, M.; Hussain, H.I.; Arioli, T.; Cahill, D. Phaeophyceaean (Brown Algal) Extracts Activate Plant Defense Systems in Arabidopsis thaliana Challenged with Phytophthora cinnamomi. Front. Plant Sci. 2020, 11, 852. [Google Scholar] [CrossRef] [PubMed]
- Wojtaszek, P. Oxidative burst: An early plant response to pathogen infection. Biochem. J. 1997, 322, 681–692. [Google Scholar] [CrossRef] [PubMed]
- Bulgakov, V.P.; Gorpenchenko, T.Y.; Veremeichik, G.N.; Shkryl, Y.N.; Tchernoded, G.K.; Bulgakov, D.V.; Aminin, D.L.; Zhuravlev, Y.N. The rolB Gene Suppresses Reactive Oxygen Species in Transformed Plant Cells through the Sustained Activation of Antioxidant Defense. Plant Physiol. 2012, 158, 1371–1381. [Google Scholar] [CrossRef]
- Di Rico, F.; Vuolo, F.; Puglisi, E. Evaluating the Role of Viable Cells, Heat-Killed Cells or Cell-Free Supernatants in Bacterial Biocontrol of Fungi: A Comparison Between Lactic Acid Bacteria and Pseudomonas. Microorganisms 2025, 13, 105. [Google Scholar] [CrossRef]
Disclaimer/Publisher’s Note: The statements, opinions and data contained in all publications are solely those of the individual author(s) and contributor(s) and not of MDPI and/or the editor(s). MDPI and/or the editor(s) disclaim responsibility for any injury to people or property resulting from any ideas, methods, instructions or products referred to in the content. |
© 2025 by the authors. Licensee MDPI, Basel, Switzerland. This article is an open access article distributed under the terms and conditions of the Creative Commons Attribution (CC BY) license (https://creativecommons.org/licenses/by/4.0/).